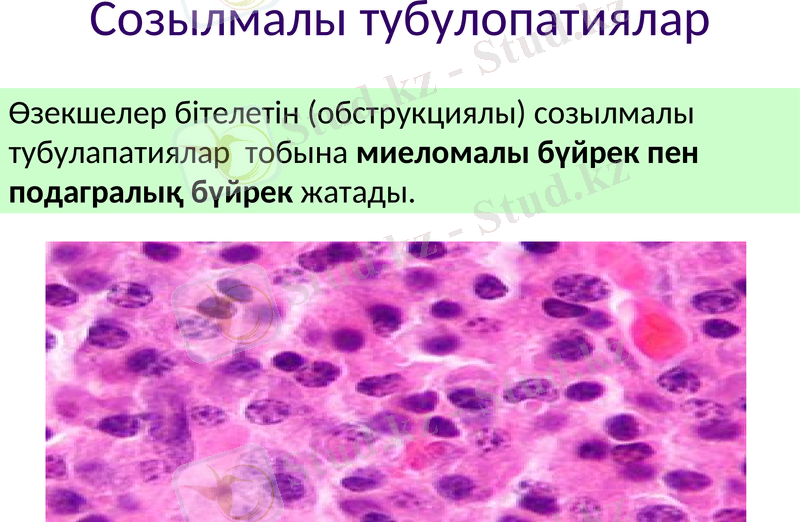
Slide 19

Тубулопатиялар және нефроздық синдром: жедел және созылмалы аспектілер



ПРЕЗЕНТАЦИЯ
Оңтүстік Қазақстан медицина академиясы
Патологиялық анатомия және гистология кафедрасы
Тақырыбы: Тубулопатиялар. Нефроздық синдром.
Орындаған: Жаркын Ж. А.
Тобы: В-СТҚБ-01-19
Қабылдаған: Досыбаев Бақытжан
2021

Жоспар:
Тубулопатиялар;
Жедел бүйрек жетіспеушілігі;
Созылмалы тубулопатиялар.
Тубулоинтерстициалды нефрит;
Нефроздық синдром;
Липоидтық нефроз;
Мембраноздық нефроз;
Пайдаланылған әдебиеттер тізімі.


Құрылым-қызметтік тұрғыдан, бүйрек ауруларын, яғни нефропатияларды, - гломерулапатиялар мен тубулапатиялар тобына жіктеуге болады, ал олардың әрқайсысы жүре пайда болуы немесе тұқым қуалауы мүмкін.

Бүйрек өзекшелерінің зақымдануы бүйректің аралық тінінде де морфологиялық өзгерістер тудырады.
Бүйректің тубулопатиялық аурулары бүйрек немесе қабыну нәтижесінде дамуы мүмкін. Алғашқы екі патологияда бүйрек өзекшелерінде дистрофиялық және некроздық өзгерістер басым болса, қабыну кезінде аралық тінде әртүрлі қабыну инфильтраттары көрінеді.

Тубулапатиялар дамығанда бірден және негізінен өзекшелер зақымдалып, бүйректің концентрациялау (зәрді қанықтыру), реабсорбциялау (қайта сору) және секрет түзуі бұзылады.

Бүйректің жедел жеткіліксіздігі - өзекшелердің эпителийінде некроз дамып, бүйректе қан- және лимфаайналымы терең зақымдалатын синдром. Бүйрек қызметінің жедел жеткіліксіздігінің морфологиялық негізі - некрозды нефроз (некронефроз) .
Тубулопатиялар
Бүйректің жедел жеткіліксіздігі

Оның негізгі себептері интоксикация мен инфекциялар. Некрозды нефроз ауыр металдардың тұздарымен, қышқылдармен, көпатомды спирттермен, наркозда қолданылатын заттармен немесе сульфаниламидтермен уланғанда байқалады. Бүйрек қызметтінің жедел жеткіліксіздігі ауыр әсерлі инфекция ауруларында орын алып, кейде бауырдың немесе бүйректің өз (гломеруланефрит, амилоидоз, тасты бүйрек ауруы) сырқаттарын асқынтады.
Этиологиясы

Некронефроз түрлі ауыр жарақаттардан (мылжалану синдромы - crusһsуndrom, операциялық бүйрек қызметінің жедел жеткіліксіздігі), көлемді күйіктен, көп мөлшерлі гемолизден («гемолиздік бүйрек»), организм сусызданғанда немесе хлорсызданғанда («хлоргидропениялық бүйрек») дамиды.

Бүйрек қызметінің жедел жеткіліксіздігі жарақаттану, улану, гемолиз, бактериялар сияқты түрлі себептерден дамыған шоктың механизмдерімен тығыз байланысты. Қанайналымын күрт бұзып, гиповолемия дамытатын, артериялық қысымды төмендетіп, шок өрістете алатын әсердің бәрі бүйрек қызметінің жедел жеткіліксіздігіне себеп бола алады. Сондықтан шок кезінде жалпы гемодинамика өзгеретіндіктен, бүйректің гемодинамикасы да бұзылып, осы аурудың патогенезінің басты буынына айналады: бүйректің қыртыстық қабатындағы тамырлар күрт тарылып (спазм), ондағы қанның басым бөлігі қыртыстық пен милыққабат аралығындағы шунттар (қосымша жол) арқылы айдалады. Қан ағысы тежелгендіктен, қыртыстық қабатында ишемия дамиды, бүйректе лимфа ағысы бұзылып, интерстиций су сіңіп ісінеді.
ПАТОГЕНЕЗІ

Патологиялық анатомиясы
Аурудың әр кезеңінің патологиялық анатомиясы біртекті емес. Оның даму барысы кезеңдерден тұрады:
бастапқы (шок)
олигоануриялық
диурез қалыпқа келетін

Бүйрек қызметінің жедел жеткіліксіздігінің қай кезеңінде болса да бүйректің сыртқы пішіні бір қалыпты. Ол қан кернеп, сусіңіп ісініп, ұлғаяды; қабығы оңай сыдырылады. Бозғылттау сұр түсті, қалыңдаған қыртыстыққабаты қоңырлау қызыл түсті пирамидалардан айқын шектеліп тұрады. Интермедиалық аймақ пен түбектерде қанды ошақтар болады. Бүйректің гистологиялық бейнесін зерттегенде аурудың кезеңдеріне сәйкес өзгерістер анықталады.

Бүйрек қызметінің жедел жеткіліксіздігінің бастапқы (шок) кезеңінде шумақ капиллярлары қабысып, бүйректің қыртыстық қабатында ишемиялық ошақтар пайда болады, интермедиалық аймақ пен пирамидаларға веналық қан іркіледі. Су сіңіп ісіну мен лимфостаз интерстицийде байқалып, интермедиалық аймақта олар айқындау болады. Өзекшелердің негізгі бөлімдеріндегі эпителийде гиалин-тамшылы, вакуольді немесе майлы дистрофия дамиды. Өзекшелердің кеңіген саңылауына цилиндрлер, кейде миоглобин кристалдары жиналады.
Бастапқы (шок) кезіндегі патологиялық анатомиялық көрінісі


Олигоануриялық кезеңде өзекшелердің басты бөлімдерін некроз шарпиды. Некроз ошақты болғанмен, өзекшелердің дистал бөлімінің базал мембранасы да ыдырайды (тубулорексис) . Өзекшелердің әртүрлі буынының саңылауын цилиндрлер бітеп, шумақ қабығының саңылауына шумақта түзілген ультрасүзінді іркіледі. Интерстицийге сусіңе түсіп, лейкоцит шоғырлары мен қанды ошақтар пайда болады. Бүйректің веналық тамырларын қан кернеп, саңылауына көбіне тромбылар түзіледі.
Олигоануриялық кезіндегі патологиялық анатомиялық көрінісі

Диурез қалпына келетін кезеңдешумақтардың біразын қан кернеп, бүйректің сусіңіп ісінуі кеміп, жасушалар шоғыры едәуір азаяды.
Бүйректе өзекшенің өлі эпителийімен қатар ашық түсті эпителийлік жасушалардан құрылған регенерат-ұялар болады. Мембраналары зақымдалмаса, өлі өзекшелер тез арада қалпына келеді. Өзекшесінің базал мембранасы жойылған нефронның орнына дәнекер тін өсіп, склероз ошақтары қалыптасады.
Диурез қалпына келетін кезеңдегі патологиялық анатомиялық көрінісі

Асқынуы
Бүйрек қызметінің жедел жеткіліксіздігінің ең ауыр зардабы - бүйректің қыртыстық қабатының сегментті немесе тотал некрозы. Ол негізінен бүйректе қанайналымы тым бұзылып, ұзақ мерзімді ишемия дамығандықтан өрістейді. Аллергиялық механизмдердің әсері де айтарлықтай маңызды.

Аурудың ақыры
Бүйрегінің қыртыстық қабатын некроз шарпығандардың да көбі өледі, бірақ гемодиализ жасап олардың өмірін ұзартуға әбден болады. Кейде бүйрек қызметінің жедел жеткіліксіздігімен сырқаттанғаннан кейін бірнеше жылдан соң бүйрек тыртықтанып бүріседі де, науқастың өліміне бүйрек қызметінің созылмалы жеткіліксіздігі себеп болады.
Өзекшелер бітелетін (обструкциялы) созылмалы тубулапатиялар тобына миеломалы бүйрек пен подагралық бүйрек жатады.
Созылмалы тубулопатиялар

Тубулоинтерстициалды нефрит деп қабынудың аралық тінде басталып, оған бүйрек өзекшелерінің немесе бүйрек түбегі мен тостағаншаларының патологиялық жағдайын түсінеміз.

Нефроздық синдром
Нефроздық синдромның дамуы бүйрек сүзгісінің өткізгіштігінің күшеюіне байланысты болып клиникада протеиурия, гипоальбуминемия, гиперлипидеммя, липидурия белгілерімен, дененің ісінуімен көрінеді. Көбінесе нефроздық синдром ересек кісілерде: жедел жүйелі қызыл жегіде, мембраноздық нейропатияда, бүйрек амилоидозында, диабеттік нефропатияда байқалып, екіншілік нефроздық синдром деп аталады. Жас балаларда нефроздық синдром бүйректің біріншілік патологиясымен байланысты, липоидты нефроз деп аталады.

Липоидтық нефроз
Негізінен 5 жасқа дейінгі балалар ауырады.
- Іс жүргізу
- Автоматтандыру, Техника
- Алғашқы әскери дайындық
- Астрономия
- Ауыл шаруашылығы
- Банк ісі
- Бизнесті бағалау
- Биология
- Бухгалтерлік іс
- Валеология
- Ветеринария
- География
- Геология, Геофизика, Геодезия
- Дін
- Ет, сүт, шарап өнімдері
- Жалпы тарих
- Жер кадастрі, Жылжымайтын мүлік
- Журналистика
- Информатика
- Кеден ісі
- Маркетинг
- Математика, Геометрия
- Медицина
- Мемлекеттік басқару
- Менеджмент
- Мұнай, Газ
- Мұрағат ісі
- Мәдениеттану
- ОБЖ (Основы безопасности жизнедеятельности)
- Педагогика
- Полиграфия
- Психология
- Салық
- Саясаттану
- Сақтандыру
- Сертификаттау, стандарттау
- Социология, Демография
- Спорт
- Статистика
- Тілтану, Филология
- Тарихи тұлғалар
- Тау-кен ісі
- Транспорт
- Туризм
- Физика
- Философия
- Халықаралық қатынастар
- Химия
- Экология, Қоршаған ортаны қорғау
- Экономика
- Экономикалық география
- Электротехника
- Қазақстан тарихы
- Қаржы
- Құрылыс
- Құқық, Криминалистика
- Әдебиет
- Өнер, музыка
- Өнеркәсіп, Өндіріс
Қазақ тілінде жазылған рефераттар, курстық жұмыстар, дипломдық жұмыстар бойынша біздің қор #1 болып табылады.



Ақпарат
Қосымша
Email: info@stud.kz